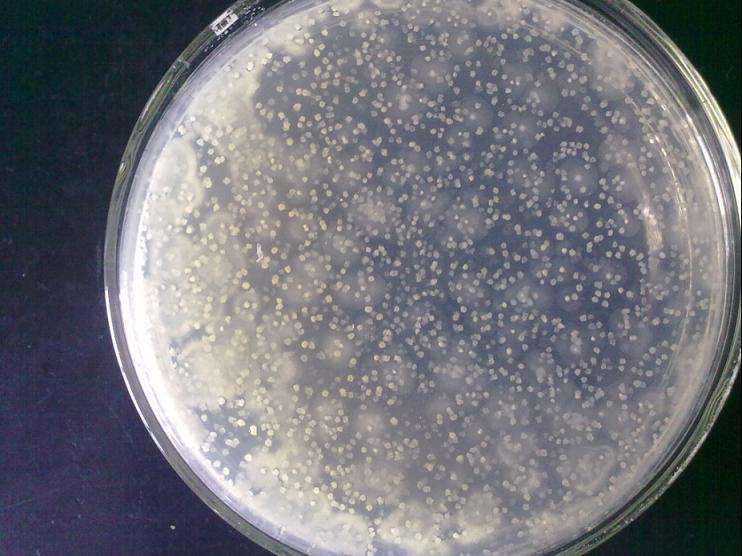

已选条件
畜渔养殖及饲料 X清空选项机构位置
不限 北京市 江苏省 山东省 广东省 浙江省 河北省 陕西省 安徽省 福建省 辽宁省 江西省 河南省 天津市 湖北省 上海市 贵州省 内蒙古 山西省 台湾省 甘肃省 云南省 湖南省 吉林省检测方式
不限样品送检现场检测机构性质
不限第三方检测机构科研院所测试中心高校测试中心/实验室其他
检测服务检索结果一览

淀粉含量、混合均匀度(预混料、配合料)、胃蛋白酶消化率、叶黄素、化学需氧量、石油类、常见致病菌(如金黄葡萄菌,沙门氏菌)、螨、膳食纤维(蔬果)
报告类型:电子文档
发布机构:广东省农业科学院公共监测中心

维生素原料:VA、VE、VD3(只能做多维,预混料)、VK3(只做单品)、泛酸钙、VB1、VB12、生物素(只做单品)、叶酸;多维:VA、VE(生育酚)、VD3、泛酸钙、叶酸、VB2、VB1、VB6、烟酸;复合预混料:VA、VE
报告类型:电子文档
发布机构:广东省农业科学院公共监测中心

维生素原料: VB2、VB6、烟酸、烟酰胺等滴定法项目
报告类型:电子文档
发布机构:广东省农业科学院公共监测中心

碳水化合物
报告类型:电子文档
发布机构:广东省农业科学院公共监测中心
菌落总数、大肠菌群、霉菌、酵母菌等常见微生物
报告类型:电子文档
发布机构:广东省农业科学院公共监测中心
热门检测服务
特色检测服务
 精选实验室,品牌服务
精选实验室,品牌服务 平台担保,安全交易
平台担保,安全交易 7*12客服,快速响应
7*12客服,快速响应 微测VLab,躺盈赚钱
微测VLab,躺盈赚钱
 首页
首页







